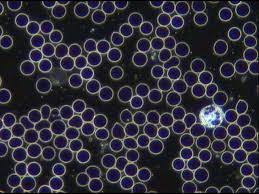

Blood can serve as a predictor of health and provide an indication of illness well before symptoms appear
- Lee Marais
- Jan 12
- 4 min read

Live Blood Analysis involves taking a single living drop of blood from the finger-tip which is then placed under a powerful microscope. The image is then displayed on a screen for both the practitioner and patient to view.
Blood transports oxygen, nutrients and other life-giving agents throughout the body to maintain health.
It is also the medium for detoxification, delivering cellular waste to the liver and kidneys for elimination from the body.
Blood can, therefore, serve as a predictor of health and provide an indication of illness well before symptoms appear.
This method of analysis is different from the usual laboratory tests that quantify the levels of certain components in a sample of blood. Live blood screening gives an indication as to the QUALITY of an individual’s blood – an important foundation of preventative health care showing the effects that diet, lifestyle and stress can have on our well-being.

Studying the shape and functioning of blood cells and plasma with a microscope can show signs of:
Poor digestion/poor food combining.
Weakened immune system.
Vitamin deficiencies
Bowel and Liver toxicity
Dehydration
Stress
Increased cholesterol & crystal formations.
Poor circulation.
Heavy metal accumulation.
Presence of parasites / fungi / bacteria.
Dark field microscopy is a procedure of analyzing blood in greater detail to gather information about the terrain, the immune system and the nutritional status of the patient. It is a way of studying live whole blood cells under a specially adapted microscope that projects the image of the live blood on to the Video.

It usually takes approx. 30 minutes to perform the test. It is carried out by first withdrawing a very small drop of blood from the patient’s fingertip. The fresh drop of blood is then placed on a clean microscope slide and viewed under the microscope which projects the image on to the video screen, allowing the practitioner and the patient to see the state of health of the blood cells as well as the presence or absence of harmful bacteria and other microorganisms.
Depending on the irregularities found in the blood, the Live blood Cell analysis can reveal the following:
Immune System Function
Free Radical Cellular Damage
Cell Size & Shape Abnormalities
Early Recognition of Cardiovascular Risk Factors
Essential Fatty Acid Deficiencies
Vitamin & Mineral Deficiencies
Digestive Disorders
Low Iron/Anaemia
Atherosclerotic Plaque
Allergies Tendencies
Hormonal Imbalances
Uric Acid Crystal & Risk for Gout
Kidney/Liver/Spleen Stress
Chemical/Heavy Metal Toxicity
Degenerative Disorders
Parasites
Dehydration
Poor Blood Circulation
Clotting Abnormalities
Bacterial Imbalances
Yeast/Fungal Tendencies
Live Blood Analysis is a comparatively new technique in the Canada but has been used in Europe extensively since the 1930's. It involves taking a single living drop of blood from the finger-tip which is then placed under a powerful microscope. The image is then displayed on a screen for both the practitioner and patient to view. Blood transports oxygen, nutrients and other life-giving agents throughout the body to maintain health. It is also the medium for detoxification, delivering cellular waste to the liver and kidneys for elimination from the body. Blood can therefore serve as a predictor of health and provide an indication of illness well before symptoms appear.
The Benefits:
Live blood screening is both educational and motivational. Clients are able to see a live picture of their own blood and their treatment progress can be visually monitored over a period of time. With changes to diet and lifestyle, improvements in the condition of the blood can sometimes be seen within a short space of time and usually within weeks. This creates a powerful incentive for patients to be more proactive in improving their health, taking responsibility for their own progress by continuing with the recommended lifestyle changes.
Did you know that your body rots and rusts?

Probably one of the most important findings that we obtain from live blood analysis is the evidence of infection, often this infection is low grade with no obvious symptoms. Prolonged infection most frequently is found taking place under a root canalled tooth. When the nerve has been removed you no longer feel pain from an infected tooth this allows the infection to spread into the jaw bone and cause serious damage to the jaw bone and immune system. Over time the constant low grade infection can lead to many health problems.
If you have root canals and currently have heart disease, cancer, or another unexplained illness it is definitely a good idea to have your blood checked for low grade infection. Dental infections from root canals are often referred to in Europe as " The Silent Killer".
Signs of infection and higher pathological lifecycles show up in the blood long before the symptoms are felt or serious disease shows up so it is a good idea to be proactive and have your blood examined.
So are you ready to "see" what your body is telling you? Book in for a Live Blood Analysis OR a FULL HEAD TO TOE "SERVICE". This includes the following:
A 60 minute Full body scan
A 30 minutes Detox
A 30 minute Live blood analysis
Contact us for more information

Comments